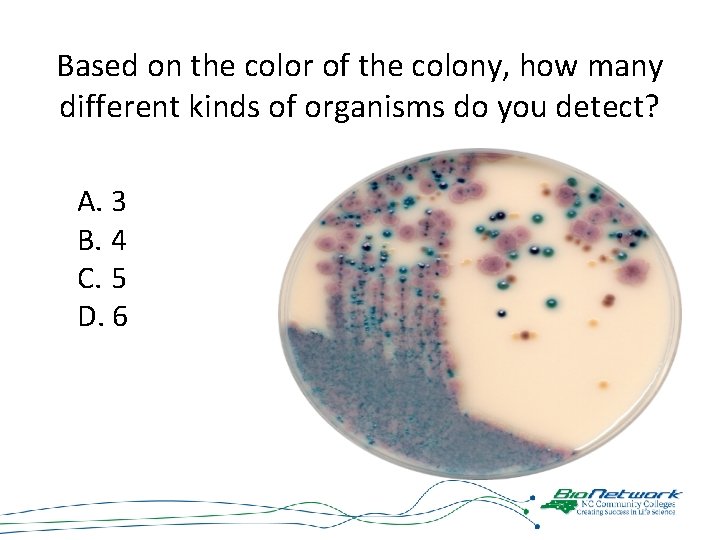
Based on the color of the colony, how many different kinds of organisms do

Microbe Mission BC NC Science Olympiad MICROBES Microbe

Microbe Mission B/C NC Science Olympiad

MICROBES… • Microbe short for microorganism (small organism that can only be observed with a microscope) • Over 99% of microbes contribute to the quality of human life • A small minority cause disease in humans by sheer numbers or producing powerful toxins • The major groups of microbes are – – – bacteria Archaea algae fungi protozoa viruses • In terms of numbers, microbes represent most of the diversity of life on Earth and are found in every environment.

Which of the following topics will be covered in this year’s event? A. Major Groups of Microbes B. Microbes and Ecology C. Microbes and Industry D. Microbes and Food E. Microbes and Disease

Which of the following topics will be covered in this year’s event? A. Major Groups of Microbes B. Microbes and Ecology C. Microbes and Industry D. Microbes and Food E. Microbes and Disease

What is each team allowed to bring with them to the event? A. One 3 -ring binder (any size) of notes B. One 8 ½ x 11” sheet of notes (double sided) C. Two non-graphing/non-programmable calculators D. A and C E. B and C

What is each team allowed to bring with them to the event? A. One 3 -ring binder (any size) of notes B. One 8 ½ x 11” sheet of notes (double sided) C. Two non-graphing/non-programmable calculators D. A and C E. B and C

What is each team required to bring with them to the event? A. Writing instrument B. Safety goggles C. Both A and B

What is each team required to bring with them to the event? A. Writing instrument B. Safety goggles C. Both A and B

What EXACTLY do my students need to know for this event? Well, since you asked…

What type of microscope provided the image below? A. Light Microscope B. Transmission Electron Microscope C. Scanning Electron Microscope D. Auto-phosphorylating Microscope

What type of microscope provided the image below? A. Light Microscope B. Transmission Electron Microscope C. Scanning Electron Microscope D. Auto-phosphorylating Microscope

Principles of Microscopy • KNOW: Types of Microscopes – their uses, advantages and disadvantages • KNOW: Parts of a Light Microscope and their function • BE ABLE TO: Properly use a microscope to view a slide • BE ABLE TO: determine total magnification and field of view • BE ABLE TO: Estimate/calculate the size of a microbe based on scales in pictures or microscopic information and amount of the visual field occupied

Which of the following is NOT a major group of microbes? A. B. C. D. Prions Ursa Algae Fungi

Which of the following is NOT a major group of microbes? A. B. C. D. Prions Ursa Algae Fungi

MAJOR GROUPS OF MICROBES • • Prions Viruses Archaea Bacteria Algae Protozoa Fungi Parasitic Worms

Acellular microbes have the ability to metabolize organic materials. A. True B. False

Acellular microbes have the ability to metabolize organic materials. A. True B. False

Cellular vs. Acellular • Acellular – – Viruses do not have cellular components, nor do they grow or metabolize organic materials. They generally consist of a piece of nucleic acid encased in protein which must use the cellular components of a living cell to reproduce. – Prions (proteinaceous infectious particles) are infectious agents composed primarily of protein which induce the existing polypeptides in host cells to take on its form. • Cellular – bacteria and Archaea are prokaryotic cells while algae, fungi, and protozoa have eukaryotic cells.

Prokaryotic vs. Eukaryotic • Prokaryotic – single cell with nuclear material but no nuclear membrane or membrane bound organelles • Eukaryotic – most cells – with organized nucleus and membrane bound organelles

Which of the following organelles are believed to have originated as prokaryotic cells? A. B. C. D. E. Mitochondrion Chloroplasts Golgi Apparatus Both A and B Both B and C

Which of the following organelles are believed to have originated as prokaryotic cells? A. B. C. D. E. Mitochondrion Chloroplasts Golgi Apparatus Both A and B Both B and C

Organelles of Microbial Origin – Mitochondria – have DNA similar to that of a Prokaryotic cell and can reproduce independent of the rest of the Eukaryotic cell. – Chloroplasts – also have DNA similar to that of a Prokaryotic cell and can reproduce independent of the rest of the Eukaryotic cell. – It is believed that both chloroplasts and mitochondria were once independent Prokaryotes who took up residence in the Eukaryotic cell and have developed a special symbiotic relationship

What is the size range for eukaryotic cells? A. B. C. D. 10 -10 m to 10 -9 m 10 -8 m to 10 -7 m 10 -6 m to 10 -5 m 10 -4 m to 10 -3 m

What is the size range for eukaryotic cells? A. B. C. D. 10 -10 m to 10 -9 m 10 -8 m to 10 -7 m 10 -6 m to 10 -5 m 10 -4 m to 10 -3 m

RELATIVE SIZE OF MICROBES

Which phase of the microbial growth curve is characterized by having the same number of cells dying as dividing? A. B. C. D. E. Lag Phase Log or Exponential Phase Stationary Phase Death Logarithmic Decline Phase

Which phase of the microbial growth curve is characterized by having the same number of cells dying as dividing? A. B. C. D. E. Lag Phase Log or Exponential Phase Stationary Phase Death Logarithmic Decline Phase

MICROBIAL GROWTH CURVE

Which of the following is NOT a bacterial shape? Division C ONLY!!! A. B. C. D. E. Cocci Bacilli Spirochete Spirilla Vibrum

Which of the following is NOT a Division C ONLY!!! bacterial shape? A. B. C. D. E. Cocci Bacilli Spirochete Spirilla Vibrum

Division C ONLY!!!

Division C ONLY!!! When applying Gram Stain, Gram (+) bacteria will stain red. A. True B. False

Division C ONLY!!! When applying Gram Stain, Gram (+) bacteria will stain red. A. True B. False

Division C ONLY!!! GRAM + VS. GRAM – BACTERIA Gram positive bacteria • stain purple under Gram stain • have a thick bilayer wall of the polymer peptidoglycan. Gram negative bacteria • stain red • have a thin layer of this polymer and an additional lipopolysaccharide outer layer, LPS, • often endotoxic - capable of initiating inflammation and cell-mediated immune responses • e. g. , Salmonella, Shigella, and Escherichia.

Which of the following statements are true for animal-like protists (protozoa)? A. Protozoans hunt other microbes for food. B. Protozoan digestion occurs in digestive organelles. C. Certain protozoa can cause dysentery and malaria. D. All of the above statements are true regarding protozoans.

Which of the following statements are true for animal-like protists (protozoa)? A. Protozoans hunt other microbes for food. B. Protozoan digestion occurs in digestive organelles. C. Certain protozoa can cause dysentery and malaria. D. All of the above statements are true regarding protozoans.

One teaspoon of topsoil contains approximately ______ fungi. A. B. C. D. 1, 200 12, 000 120, 000 1, 200, 00

One teaspoon of topsoil contains approximately ______ fungi. A. B. C. D. 1, 200 12, 000 120, 000 1, 200, 00

Fungi • Cellular level, more like animals than plants – Eukaryotic • Can’t synthesize their own food • Single celled as yeast or multicellular clusters as molds & mushrooms • Multicellular ones form filament like strands – hyphae • Grow best in slightly acidic environment – can grow in low moisture • Live in soil, on plants & animals, in fresh & salt water • One teaspoon of topsoil has about 120, 000 fungi • Baker’s yeast for bread and brewing, some are used for antibiotics, others serve as decomposers • Some cause disease in humans, animals and plants – ruin ¼ to ½ of fruits & vegetables per year
Based on the color of the colony, how many different kinds of organisms do you detect? A. 3 B. 4 C. 5 D. 6

Based on the color of the colony, how many different kinds of organisms do you detect? A. 3 B. 4 C. 5 D. 6

Which of the following is an incorrect pairing of microbe with the disease it can cause? A. B. C. D. Virus/Tetanus Prion/Kuru Fungus/Dutch Elm Disease Protozoan/Malaria

Which of the following is an incorrect pairing of microbe with the disease it can cause? A. B. C. D. Virus/Tetanus Prion/Kuru Fungus/Dutch Elm Disease Protozoan/Malaria

VIRAL DISEASES • • • AIDS Chicken Pox & Shingles Common Cold Dengue Fever Ebola Hemorrhagic Fever Hepatitis Influenza Measles Mumps • • Mononucleosis Polio Rabies Rubella Small pox West Nile Fever Yellow Fever

BACTERIAL DISEASES • • Anthrax Botulism Chlamydiasis Cholera Dental Caries (tooth decay) Legionnaire's Disease Lyme Disease MRSA • Peptic Ulcer Disease • Pertussis (whooping cough) • Rocky Mountain Spotted Fever • Strep throat • Syphilis • Tetanus • Tuberculosis

FUNGAL DISEASES • • Athlete’s foot Dutch Elm Disease Ergotism Histoplasmosis Potato Blight Ringworm Thrush

PROTOZOAN/ALGAL DISEASES • • • Malaria Paralytic Shellfish Poisoning Estuary Associated Syndrome Giradiasis Cryptosporidiosis

PRION DISEASE • Scrapie • Kuru

PARASITIC WORMS • • • Hookworm Pinworm Schistosomiasis Tapeworm Trichinosis

Additional Resources: • Microbe Mission National Page – 2017 List of Diseases – 2017 Power. Point – Event Supervisor Guide • Centers for Disease Control • Brain. Pop! • Questions: – Erin Bingham – Courtney Behrle ebingham@ncbionetwork. org cbehrle@ncbionetwork. org
- Slides: 50